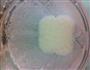
核桃酪的做法图解8

| 核桃酪热量分析 (可根据实际输入食材份量计算。数据仅供参考) | |||||
|---|---|---|---|---|---|
| 食材名称 | 食材份量 | 热量 | 标准度量(每100克) | 蛋白质 | 脂肪 |
| 核桃 | 克 | 654千卡 | 654千卡 | 15.23克 | 65.209999克 |
| 糯米 | 克 | 142千卡 | 355千卡 | 6.3克 | 0.6克 |
| 红枣 | 克 | 388千卡 | 264千卡 | 3.2克 | 0.5克 |
| 冰糖 | 克 | 560千卡 | 397千卡 | 0克 | 0克 |
| 总量 | 428克 | 核桃酪热量/卡路里1744千卡 | |||

1/11. 糯米提前浸泡1小时以上

2/11. 用沸水泡核桃

3/11. 耐心地剥去核桃的外皮

4/11. 红枣泡一会

5/11. 把红枣核去掉

6/11. 把准备好的食材倒入料理机

7/11. 加适量水一起打浆
8/11. 启动机器

9/11. 把打好的浆倒回锅里煮,可以过滤,我没有过滤

10/11. 加适量冰糖一起煮

11/11. 一边煮一定要同时搅拌,直到煮开而且变浓稠即可
核桃的热量654千卡(每100克);有利含量:低胆固醇,低钠盐,低饱和脂肪酸,富含维生素E,富含蛋白质;具有滋养脑细胞、抗癌、缓解疲劳等功效;可与马蹄、黑芝麻、梨搭配;与野鸡肉、黄豆、鳖肉相克,同食可能会引起不适;
糯米的热量355千卡(每100克);有利含量:低胆固醇,低钠盐,低饱和脂肪酸,富含钾;具有补虚、护发明目、止汗等功效;可与莲藕、枣(鲜)、桑葚搭配;与莲子、鸡肉、鸡胸肉相克,同食可能会引起不适;
红枣的热量264千卡(每100克);具有除腥臭怪味、保肝护肝、防癌等功效;可与南瓜、冬瓜、黑木耳搭配;与胡萝卜、鱼肉、虾皮相克,同食可能会引起不适;
冰糖的热量397千卡(每100克);有利含量:低胆固醇,低钠盐,低饱和脂肪酸;具有清热除火、解毒、润肺止咳等功效;可与银耳、鸭梨、五味子搭配;